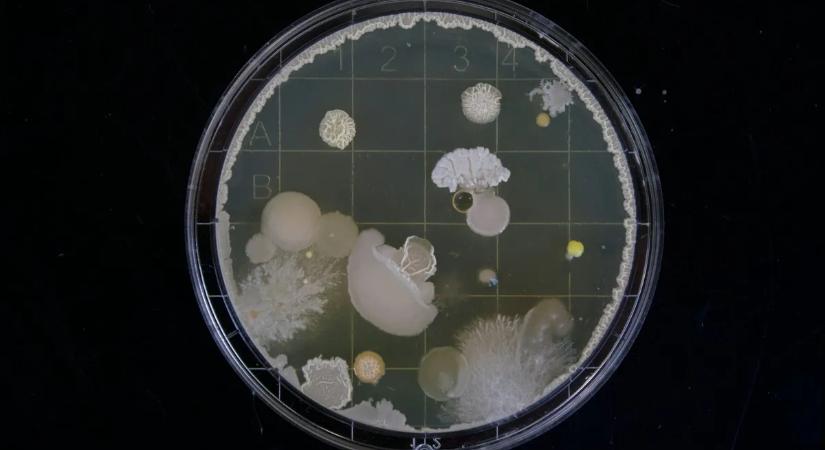
Ez megváltoztathatja a gyógyítást! Itt a fegyver a szuperbaktériumok ellen

Ez megváltoztathatja a gyógyítást! Itt a fegyver a szuperbaktériumok ellen
Fordulópont a gyógyszerrezisztens fertőzések kezelésében.

Hamarosan átirányítunk a teljes cikkhez → Origo
Fordulópont a gyógyszerrezisztens fertőzések kezelésében.
Hamarosan átirányítunk a teljes cikkhez → Origo